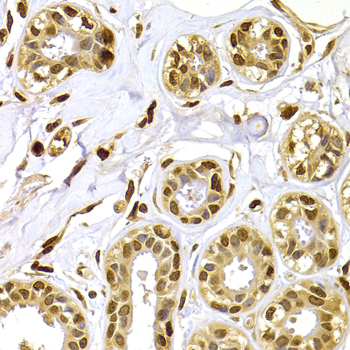
A1631: image 3

For quotations, please use our online quotation form, and you may also contact us by
sales@neoscientific.com
+1-888.733.6849
+1-617.299.7367 (Int’l)
+1-888.733.6849
+1-617.299.7367 (Int’l)
| Reactivity | Human Mouse Rat |
| Tested applications | WB IHC |
| Recommended Dilution | WB 1:500 - 1:2000 IHC 1:50 - 1:200 |
| Calculated MW | 12kDa |
| Observed MW | Refer to Figures |
| Immunogen | Recombinant protein of human S100A4 |
| Storage Buffer | Store at -20℃. Avoid freeze / thaw cycles. Buffer: PBS with 0.02% sodium azide, 50% glycerol, pH7.3. |
| Concentration | j |
| Synonym | 42A; 18A2; CAPL; FSP1; MTS1; P9KA; PEL98; |

Western blot analysis of extracts of various cell lines, using S100A4 antibody.

Immunohistochemistry of paraffin-embedded rat brain using S100A4 antibody at dilution of 1:100 (x400 lens).
Immunohistochemistry of paraffin-embedded human breast using S100A4 antibody at dilution of 1:100 (x400 lens).

Immunohistochemistry of paraffin-embedded human stomach cancer using S100A4 antibody at dilution of 1:100 (x400 lens).

Immunohistochemistry of paraffin-embedded mouse lung using S100A4 antibody at dilution of 1:100 (x400 lens).
The protein encoded by this gene is a member of the S100 family of proteins containing 2 EF-hand calcium-binding motifs. S100 proteins are localized in the cytoplasm and/or nucleus of a wide range of cells, and involved in the regulation of a number of cellular processes such as cell cycle progression and differentiation. S100 genes include at least 13 members which are located as a cluster on chromosome 1q21. This protein may function in motility, invasion, and tubulin polymerization. Chromosomal rearrangements and altered expression of this gene have been implicated in tumor metastasis. Multiple alternatively spliced variants, encoding the same protein, have been identified. [provided by RefSeq, Jul 2008]
N/A